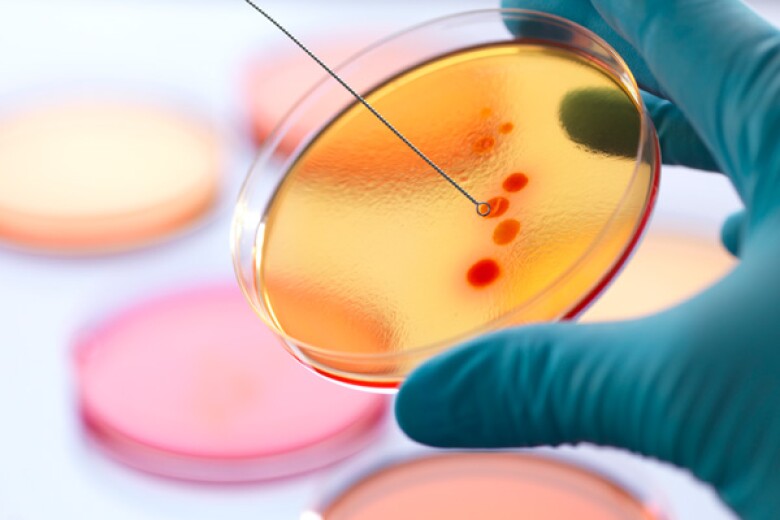
scientist collecting a sample from a petri dish

Make your data AI-ready faster
Ready for AI. Ready for regulations. Ready for growth. Ready for new opportunities.
Be already ready for any new mission-critical initiative.
Be already ready for any new mission-critical initiative.
We're different by design
InterSystems isn’t just another data company—we’re different by design.
InterSystems delivers unparalleled speed and reliability with a unique architecture that brings processing closer to the data.
Trusted across industries, we’re proud to be the platform of choice for the world’s most critical applications.
InterSystems delivers unparalleled speed and reliability with a unique architecture that brings processing closer to the data.
Trusted across industries, we’re proud to be the platform of choice for the world’s most critical applications.
Built to Solve Complex Challenges
Our solutions help organizations in every industry address their toughest, most critical problems to move their business—and the world—forward.
Jun 17, 2021
Our healthcare solutions are based on a common set of interoperability services, with support for virtually every major health standard.
Jul 05, 2021
Our solutions empower financial services firms to transform at scale to increase customer satisfaction, adopt generative AI, and maintain compliance.
Jul 05, 2021
Organizations leverage our technology to enable better decision making, streamline processes and provide real-time visibility across their supply chains.

InterSystems Interoperability: Powerful, Flexible Integration
A better way to bridge, orchestrate, monitor and manage data silos that seamlessly supports enterprise data fabric initiatives.

Accelerate your enterprise data initiatives with a smart data fabric
InterSystems Data Studio™ provides the fastest path to a smart data fabric.
The InterSystems Difference
We Bring the Processing to the Data
Our approach means less moving of data. That means less potential for data errors, faster processing, greater security, and lower costs.
Easy to Learn, Easy to Use
InterSystems technologies are designed so users can quickly and easily create and maintain a smart data fabric.
Unique Architectural Approach
Our integrated, interoperable, multi-model, multi-lingual engine provides the highest performance and resiliency with the lowest TCO.
Fast Time to Value
Our industry-specific solution bundles allow users to quickly realize the benefits of a smart data fabric.
Industry-Leading Support
We're focused on making our customers successful and ready for any challenge, which is demonstrated by some of the highest customer satisfaction ratings in the category.
Powering the World’s Most Important Applications
Our software powers mission-critical applications in nearly every industry — from healthcare and financial services to supply chain and space exploration.
Learn how customers across the globe are implementing our technologies to achieve business goals.
Jun 16, 2023
By implementing InterSystems Smart Data Fabric, Harris Associates breaks down data silos reducing the time it takes to make informed business decisions.
Jul 27, 2024
eHealth Exchange interconnects tens of thousands of distinct healthcare entities and facilitates over 21 billion secure transactions a year using InterSystems technology.
Trusted by Global Leaders

InterSystems READY 2026
April 27 - April 30, 2026 | National Harbor, Maryland
Are You Ready for the Future?
InterSystems READY 2026 event is a friendly and informative gathering for the InterSystems community to meet, interact, and exchange knowledge.
READY 2026 includes the InterSystems Healthcare Leadership Conference, our by invitation-only gathering for executives from health and life sciences organizations around the world.
Learn More & Register Now
InterSystems READY 2026 event is a friendly and informative gathering for the InterSystems community to meet, interact, and exchange knowledge.
READY 2026 includes the InterSystems Healthcare Leadership Conference, our by invitation-only gathering for executives from health and life sciences organizations around the world.
Learn More & Register Now

“InterSystems IRIS data platform gives power to configure and code in an easy, robust way that offers flexibility.”
- Jonathan Dover, Director of Technology @ Epic
Get started in less than a minute using a web-based IDE.
Healthy data matters
Making a powerful impact on the health of data across multiple sectors. Is your data healthy?
1 Billion
Health records managed using InterSystems technology across the world
+300K
Transactions processed per day for the world's largest container shipping company
100%
Percentage of hospitals on the U.S. News & World Report Honor Roll use our products